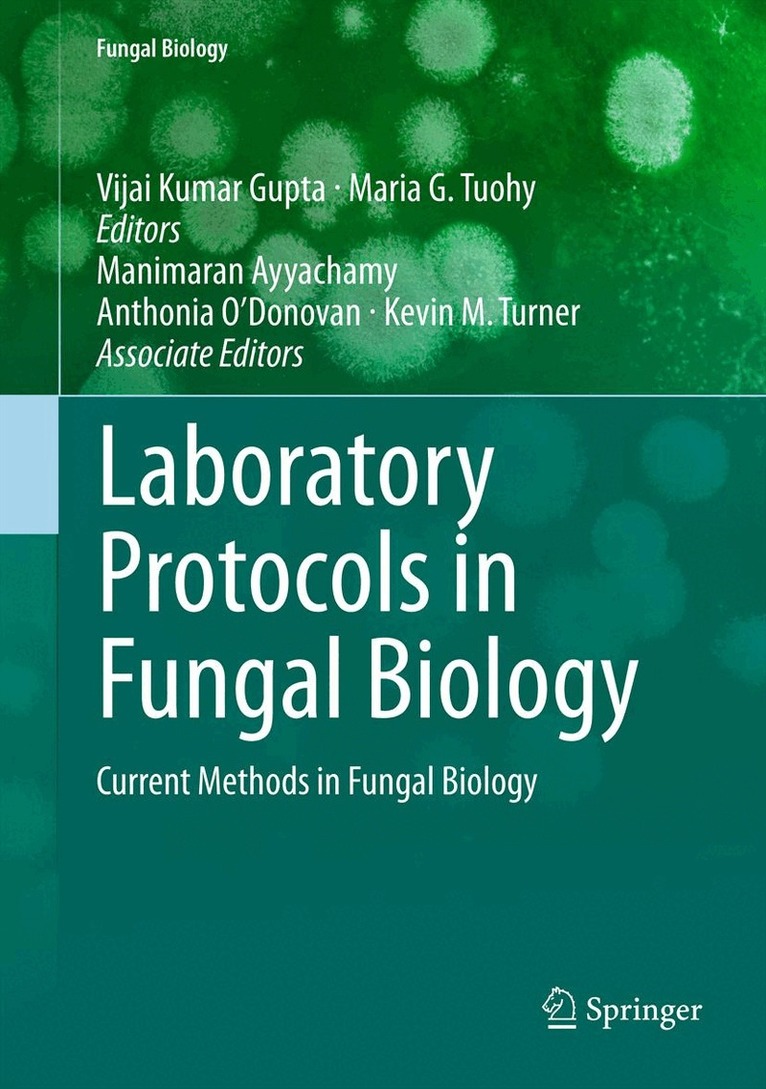

Maria G. Tuohy – författare
3 251 kr
Läs direkt efter köp
Bioactive compounds play a central role in high-value product development in the chemical industry. Bioactive compounds have been identified from diverse sources and their therapeutic benefits, nutritional value and protective effects in human and animal healthcare have underpinned their application as pharmaceuticals and functional food ingredients. The orderly study of biologically active products and the exploration of potential biological activities of these secondary metabolites, including their clinical applications, standardization, quality control, mode of action and potential biomolecular interactions, has emerged as one of the most exciting developments in modern natural medicine.
Biotechnology of Bioactive Compounds describes the current stage of knowledge on the production of bioactive compounds from microbial, algal and vegetable sources. In addition, the molecular approach for screening bioactive compounds is also discussed, as well as examples of applications of these compounds on human health. The first half of the book comprises information on diverse sources of bioactive compounds, ranging from microorganisms and algae to plants and dietary foods. The second half of the book reviews synthetic approaches, as well as selected bioactivities and biotechnological and biomedical potential. The bioactive compounds profiled include compounds such as C-phycocyanins, glycosides, phytosterols and natural steroids. An overview of the usage of bioactive compounds as antioxidants and anti-inflammatory agents, anti-allergic compounds and in stem cell research is also presented, along with an overview of the medicinal applications of plant-derived compounds.
Biotechnology of Bioactive Compounds will be an informative text for undergraduate and graduate students of bio-medicinal chemistry who are keen to explore the potential of bioactive natural products. It also provides useful information for scientists working in various research fields where natural products have a primary role.
3 251 kr
Läs direkt efter köp
Bioactive compounds play a central role in high-value product development in the chemical industry. Bioactive compounds have been identified from diverse sources and their therapeutic benefits, nutritional value and protective effects in human and animal healthcare have underpinned their application as pharmaceuticals and functional food ingredients. The orderly study of biologically active products and the exploration of potential biological activities of these secondary metabolites, including their clinical applications, standardization, quality control, mode of action and potential biomolecular interactions, has emerged as one of the most exciting developments in modern natural medicine.
Biotechnology of Bioactive Compounds describes the current stage of knowledge on the production of bioactive compounds from microbial, algal and vegetable sources. In addition, the molecular approach for screening bioactive compounds is also discussed, as well as examples of applications of these compounds on human health. The first half of the book comprises information on diverse sources of bioactive compounds, ranging from microorganisms and algae to plants and dietary foods. The second half of the book reviews synthetic approaches, as well as selected bioactivities and biotechnological and biomedical potential. The bioactive compounds profiled include compounds such as C-phycocyanins, glycosides, phytosterols and natural steroids. An overview of the usage of bioactive compounds as antioxidants and anti-inflammatory agents, anti-allergic compounds and in stem cell research is also presented, along with an overview of the medicinal applications of plant-derived compounds.
Biotechnology of Bioactive Compounds will be an informative text for undergraduate and graduate students of bio-medicinal chemistry who are keen to explore the potential of bioactive natural products. It also provides useful information for scientists working in various research fields where natural products have a primary role.
2 122 kr
Läs direkt efter köp
Showcases the recent advances in microbial functional food applications across food science, microbiology, biotechnology, and chemical engineering
Microbial technology plays a key role in the improvement of biotechnology, cosmeceuticals, and biopharmaceutical applications. It has turned into a subject of expanding significance because new microbes and their related biomolecules are distinguished for their biological activity and health benefits. Encompassing both biotechnology and chemical engineering, Microbial Functional Foods and Nutraceuticals brings together microbiology, bacteria, and food processing/mechanization, which have applications for a variety of audiences. Pharmaceuticals, diagnostics, and medical device development all employ microbial food technology.
The book addresses the recent advances in microbial functional foods and associated applications, providing an important reference work for graduates and researchers. It also provides up-to-date information on novel nutraceutical compounds and their mechanisms of action—catering to the needs of researchers and academics in food science and technology, microbiology, chemical engineering, and other disciplines who are dealing with microbial functional foods and related areas.
Microbial Functional Foods and Nutraceuticals is:
Ground-breaking: Includes the latest developments and research in the area of microbial functional foods and nutraceuticals Multidisciplinary: Applicable across food science and technology, microbiology, biotechnology, chemical engineering, and other important research fields Practical and academic: An important area of both academic research and new product development in the food and pharmaceutical industriesMicrobial Functional Foods and Nutraceuticals is an ideal resource of information for biologists, microbiologists, bioengineers, biochemists, biotechnologists, food technologists, enzymologists, and nutritionists.
2 122 kr
Läs direkt efter köp
Showcases the recent advances in microbial functional food applications across food science, microbiology, biotechnology, and chemical engineering
Microbial technology plays a key role in the improvement of biotechnology, cosmeceuticals, and biopharmaceutical applications. It has turned into a subject of expanding significance because new microbes and their related biomolecules are distinguished for their biological activity and health benefits. Encompassing both biotechnology and chemical engineering, Microbial Functional Foods and Nutraceuticals brings together microbiology, bacteria, and food processing/mechanization, which have applications for a variety of audiences. Pharmaceuticals, diagnostics, and medical device development all employ microbial food technology.
The book addresses the recent advances in microbial functional foods and associated applications, providing an important reference work for graduates and researchers. It also provides up-to-date information on novel nutraceutical compounds and their mechanisms of action—catering to the needs of researchers and academics in food science and technology, microbiology, chemical engineering, and other disciplines who are dealing with microbial functional foods and related areas.
Microbial Functional Foods and Nutraceuticals is:
Ground-breaking: Includes the latest developments and research in the area of microbial functional foods and nutraceuticals Multidisciplinary: Applicable across food science and technology, microbiology, biotechnology, chemical engineering, and other important research fields Practical and academic: An important area of both academic research and new product development in the food and pharmaceutical industriesMicrobial Functional Foods and Nutraceuticals is an ideal resource of information for biologists, microbiologists, bioengineers, biochemists, biotechnologists, food technologists, enzymologists, and nutritionists.
1 810 kr
Skickas inom 11-20 vardagar
3 231 kr
Skickas inom 10-15 vardagar
3 046 kr
Läs direkt efter köp
Laboratory Protocols in Fungal Biology presents the latest techniques in fungal biology. This book analyzes information derived through real experiments, and focuses on cutting edge techniques in the field. The book comprises 57 chapters contributed from internationally recognised scientists and researchers. Experts in the field have provided up-to-date protocols covering a range of frequently used methods in fungal biology. Almost all important methods available in the area of fungal biology viz. taxonomic keys in fungi; histopathological and microscopy techniques; proteomics methods; genomics methods; industrial applications and related techniques; and bioinformatics tools in fungi are covered and complied in one book. Chapters include introductions to their respective topics, list of the necessary materials and reagents, step-by-step, readily reproducible laboratory protocols, and notes on troubleshooting. Each chapter is self-contained and written in a style that enablesthe reader to progress from elementary concepts to advanced research techniques. Laboratory Protocols in Fungal Biology is a valuable tool for both beginner research workers and experienced professionals.
Coming Soon in the Fungal Biology series:
Goyal, Manoharachary / Future Challenges in Crop Protection Against Fungal Pathogens
Martín, García-Estrada, Zeilinger / Biosynthesis and Molecular Genetics of Fungal Secondary Metabolites
Zeilinger, Martín, García-Estrada / Biosynthesis and Molecular Genetics of Fungal Secondary Metabolites, Volume 2
van den Berg, Maruthachalam / Genetic Transformation Systems in Fungi
Schmoll, Dattenbock / Gene Expression Systems in Fungi
Dahms / Advanced Microscopy in Mycology
2 361 kr
Skickas inom 10-15 vardagar
3 354 kr
Skickas inom 5-8 vardagar
2 156 kr
Skickas inom 10-15 vardagar
2 741 kr
Läs direkt efter köp
Biofuels are considered to be the main potential replacement for fossil fuels in the near future. In this book international experts present recent advances in biofuel research and related technologies. Topics include biomethane and biobutanol production, microbial fuel cells, feedstock production, biomass pre-treatment, enzyme hydrolysis, genetic manipulation of microbial cells and their application in the biofuels industry, bioreactor systems, and economical processing technologies for biofuel residues. The chapters provide concise information to help understand the technology-related implications of biofuels development. Moreover, recent updates on biofuel feedstocks, biofuel types, associated co- and byproducts and their applications are highlighted. The book addresses the needs of postgraduate researchers and scientists across diverse disciplines and industrial sectors in which biofuel technologies and related research and experimentation are pursued.
2 156 kr
Skickas inom 10-15 vardagar
2 187 kr
Tillfälligt slut